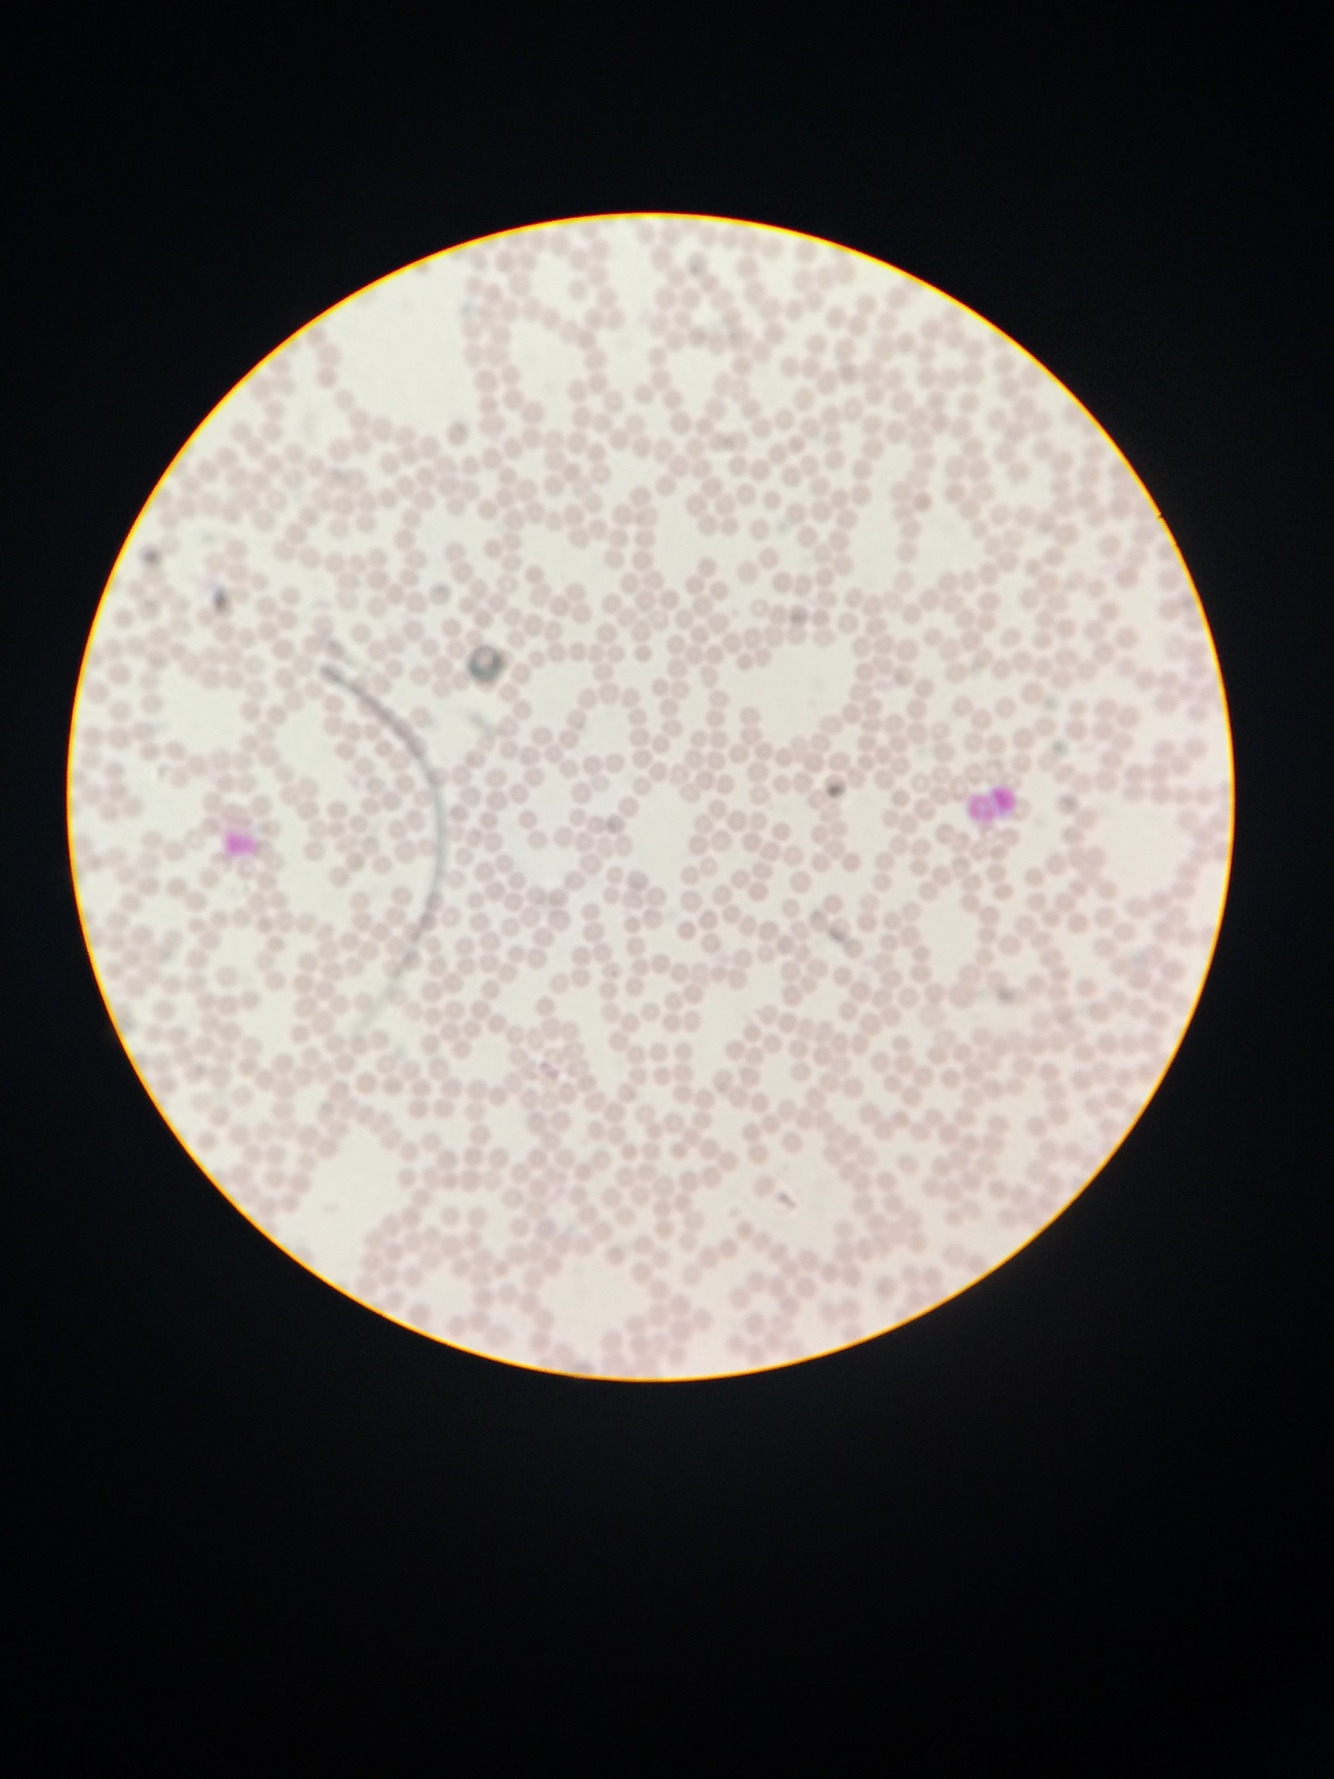

1
Q
What type of tissue is this? Name a location and function.

A
Adipose Connective Tissue
Location: Subcutaneous layer; breasts, kidneys, eyeballs
Function: Long-term energy stroage, protection, insulation
2
Q
What type of tissue is this? Name a location and function.
A
Blood Connective Tissue
Location: Heart, blood vessels, spleen
Function: Transportation of nutrients, gases and waste products
3
Q
What type of tissue is this? Name a location and function.

A
Bone Connective Tissue
Location: Bones
Function: Support hematopoiesis (production of blood cells), calcium storage, and protection


